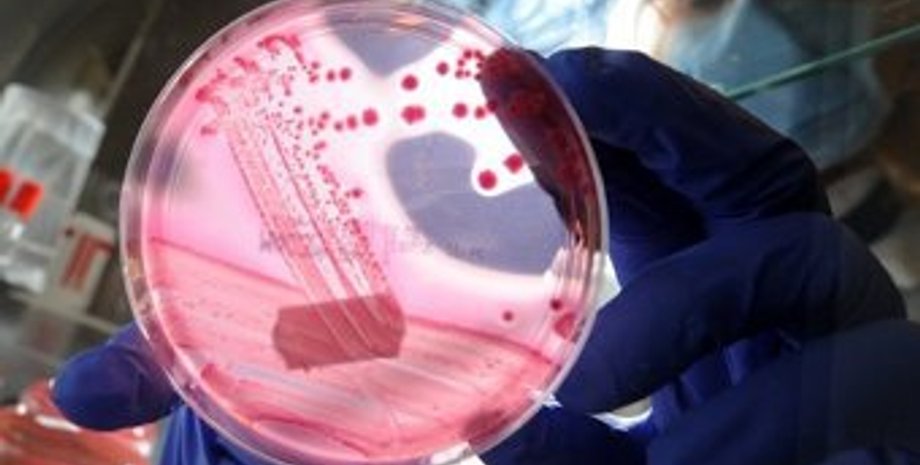

Вспышка кишечной инфекции в Германии: 10 человек умерли
В Германии жертвами кишечного заболевания, вызванного так называемой энтерогеморрагической бактерией Escherichia coli (EHEC), стали десять человек
Как передает Лента.ру, такие данные DW-WORLD. Девять из десяти скончавшихся - женщины. К субботе, 28 мая, было зафиксировано более 1000 подтвержденных и предположительных случаев заболевания. Наиболее тяжелая ситуация сложилась на севере Германии. Так, четыре летальных исхода за последние двое суток были зафиксированы в Шлезвиг-Гольштейне и Гамбурге.
В целом случаи заражения были выявлены в 15 из 16 федеральных земель Германии. Большинство заболевших - взрослые, притом у 87 процентов их них болезнь протекает в форме гемолитико-уремического синдрома (ГУС), для которого характерна гемморагическая диарея, острая почечная недостаточность и анемия.
Ученые Гамбургской университетской клиники надеются, что бороться с инфекцией поможет новое средство. По словам профессора клиники Рольфа Шталя (Rolf Stahl), шести тяжело инфицированным ввели особые антитела, которые должны помочь при острой почечной недостаточности.
Случаи инфекционной болезни, протекающей в форме ГУС, за последние дни были зафиксированы не только в ФРГ, но и в Швеции, Дании, Голландии и Великобритании. Пока неясно, имеют ли эти случаи прямое отношение к вспышке кишечной инфекции в Германии.
26 мая стало известно, что источником кишечной инфекции в ФРГ стали огурцы, импортированные из Испании. Партии огурцов, содержащих бактерии возбудителя инфекции, возможно, были импортированы также в Чехию, Австрию, Венгрию и Люксембург.
Медики считают, что пик заболевания еще не достигнут. Испания объявила о приостановке экспорта овощей от двух фирм-производителей. Пока неясно, когда кишечная палочка попала на овощи: непосредственно на базах в Испании или во время транспортировки.
